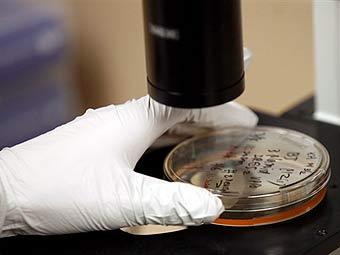

|
Фото ©AFP
|
Минздравсоцразвития утвердило перечень профессий и должностей, на которые в 2009 году не распространяются квоты по приему трудовых мигрантов. По сравнению с прошлогодним перечнем он сократился на пять пунктов. Льгот лишились биофизики, биохимики, инженеры-микробиологи, начальники отдела компьютерного обеспечения и инженеры по автоматизированным системам управления производством.
В число работников, которых Россия готова принять в неограниченном количестве, в этом году вошли топ-менеджеры предприятий - генеральные директора и директора, инженеры по защите информации, а также инженеры по автоматизации и механизации производственных процессов. Всего в список попали 17 профессий и должностей.
Замглавы Минздравсоцразвития Максим Топилин пояснил "Интерфаксу", что в 2008 году биохимики, биофизики и микробиологи в Россию почти не въезжали. Зато очень востребованными среди иностранцев оказались должности генеральных директоров: их в РФ въехало 10,6 тысячи. Всего же в страну за год въехали около 16 тысяч представителей не подлежащих квотированию профессий.
В беседе с корреспондентом Прайм ТАСС Топилин заявил, что начальник отдела компьютерного обеспечения и инженер по автоматизированным системам управления производством были вычеркнуты из перечня потому, что в условиях кризиса на эти должности начали претендовать россияне.
В 2008 году перечень профессий и должностей, обладатели которых могут въезжать в Россию в любых количествах, был утвержден впервые. Цель этого документа - за счет иностранцев обеспечить страну наиболее нужными экономике и в то же время дефицитными работниками.
В 2009 году квота на въезд гастарбайтеров в РФ составляет 3,97 миллиона человек. При изменении обстоятельств эта цифра может быть увеличена до 6 миллионов либо сокращена до 2 миллионов человек.




